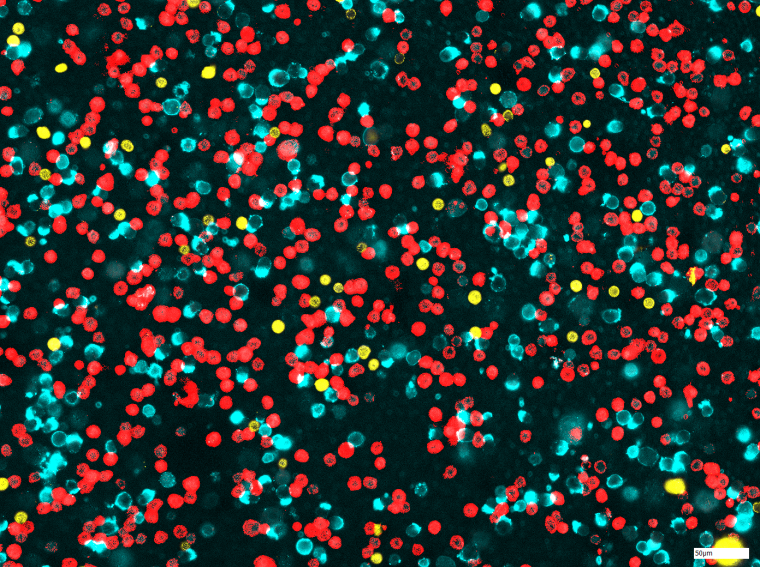
Bei der Chipzytometrie werden die Zellen auf einem Objektträger fixiert. Bei...

Immun-Check für die Lunge
Forschende des Fraunhofer-Instituts für Toxikologie und Experimentelle Medizin ITEM haben mit der Chipzytometrie ein Verfahren etabliert, mit dem man die Immunzellen der Lunge charakterisieren kann.
Bei klinischen Studien müssen die Patienten umfassend untersucht werden, um die Wirkung des neuen Medikaments genauestens zu erfassen. Ein wichtiger Punkt ist die Reaktion des Immunsystems. Forschende des Fraunhofer-Instituts für Toxikologie und Experimentelle Medizin ITEM haben mit der Chipzytometrie ein Verfahren etabliert, mit dem man die Immunzellen der Lunge charakterisieren kann. Der große Vorteil der Methode: Die wertvollen Patientenproben lassen sich über Monate im Kühlschrank lagern und auf weitere Parameter untersuchen – falls im Verlauf der klinischen Studie neue Aspekte relevant werden.
Das Immunsystem kämpft mit einer Armada hochspezialisierter Zellen gegen Infektionen. Granulozyten produzieren gegen die Erreger einen toxischen Cocktail, B-Zellen liefern spezifische Antikörper und Makrophagen fressen die Eindringlinge auf. „Je nach Krankheitsbild kommen ganz unterschiedliche Immunzellen in der Lunge vor“, erklärt Dr. Saskia Carstensen, die die Chipzytometrie am Fraunhofer ITEM in Hannover etabliert hat. „Wir untersuchen die Zellen im ausgehusteten Bronchialsekret, dem Sputum, und in der bronchoalveolären Lavage, die bei einer Lungenspülung mit Kochsalzlösung gewonnen wird.“
Automatische Auswertung der Proben
Die Patientenproben werden in einem speziellen Objektträger untersucht. Dieser Chip besteht aus einer durchsichtigen Kammer, auf deren Boden sich die Zellen anheften. Dann erfolgt die Färbung mit farbig fluoreszierenden Antikörpern, die ganz spezifisch an einen bestimmten Typ von Immunzellen binden. So lassen sich zum Beispiel Granulozyten und Makrophagen unterschiedlich färben. Die Auswertung der mikroskopischen Bilder erfolgt weitgehend automatisch. Als Ergebnis erhält man die Anteile der gesuchten Immunzellen in der Probe. „Wir können mit der Chipzytometrie nicht nur die Zelltypen voneinander unterscheiden, sondern auch sehen, ob sie aktiviert sind und zu welcher Untergruppe sie gehören“, erklärt Saskia Carstensen.
Entwickelt wurde die Chipzytometrie vom Hannoveraner Start-Up „Zellkraftwerk“, das mittlerweile im US-Unternehmen Canopy Bioscience aufgegangen ist. Zellkraftwerk hat die Technologie an Blutzellen validiert. Saskia Carstensen hat sie nun für Immunzellen aus der Lunge adaptiert. „Zellen, die mit dem Bronchialsekret ausgehustet werden, sind häufig schon voraktiviert und daher schwieriger zu verarbeiten als Blutzellen“, beschreibt Carstensen die Herausforderung. Schwierig auszuwerten sind auch die in der Lunge vorkommenden Makrophagen, da sie wesentlich größer sind als Blutzellen.
Die Entzündung lässt sich quantifizieren
In einem Modellprojekt konnte Carstensens Team zeigen, dass die Adaptation der Chipzytometrie auf Immunzellen der Lunge funktioniert. Dazu haben die Forschenden an gesunden Probanden eine Entzündung ausgelöst. Die Probanden inhalierten einen Reizstoff, der der Oberfläche krankheitserregender Bakterien ähnelt. Daraufhin wurden das Sputum und die bronchoalveoläre Lavage untersucht. Mit der Chipzytometrie konnte die Immunreaktion in der Lunge verfolgt werden. Erhöht war vor allem die Zahl von neutrophilen Granulozyten und Monozyten, aus denen in der Lunge dann Makrophagen entstehen. „Wir konnten zeigen, dass wir die Entzündung nachweisen und quantifizieren können“, erklärt die Biochemikerin.
Den klassischen Methoden überlegen
In dem Projekt wurden auch die Vorteile gegenüber den klassischen Methoden zur Zellcharakterisierung verdeutlicht. Während bei der differentiellen Zellzählung die Zelltypen manuell unter dem Mikroskop gezählt werden, erfolgt die Auswertung bei der Chipzytometrie automatisch. Auch im Vergleich zur zweiten Standardmethode, der Durchflusszytometrie, bietet das neue Verfahren Vorteile. Bei der Durchflusszytometrie werden die Proben nach der Untersuchung verworfen. Die gefärbten Zytometrie-Chips lassen sich dagegen im Kühlschrank lagern und stehen für weitere Untersuchungen und Färbungen zur Verfügung.
Ein Forschungsfeld, das das Fraunhofer-Team intensiv untersucht, ist die Wirksamkeit von neuen Prüfpräparaten gegen die chronisch obstruktive Lungenerkrankung COPD. Bei dieser stetig fortschreitenden Erkrankung leiden die Patienten unter Husten, Auswurf und zunehmender Atemnot. Eine ursächliche Therapie gibt es nicht. Von der COPD sind in Deutschland rund 6,8 Mio. Menschen betroffen. Die chronische Erkrankung ist mittlerweile die dritthäufigste Todesursache weltweit. „Wir fungieren unter anderem als Zentrallabor für multizentrische klinische Studien und lagern die Proben in einer Biobank. Unsere Technologie ist hervorragend geeignet, in klinischen Studien die Wirkung von Medikamenten gegen COPD zu monitoren“, erklärt Saskia Carstensen.














